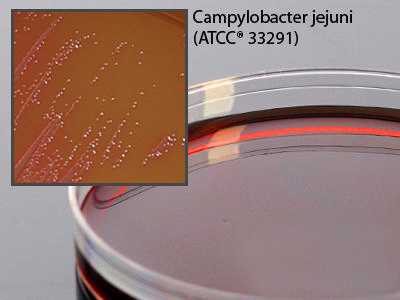

Media Campy Fda Agar 15x100mm Plate 18ml , Pack Of 10
$ 69.46
|
|
Details:
Campy FDA Agar 15x100mm plate^ Campy FDA Agar, Brucella agar with 7% lysed horse blood, polymixin, vancomycin, amphotericin and novobiocin, Modified Skirrows formula, For Campylobacter, 15x100mm plate, Fill volume: 18ml
Additional Information
| SKU | 23958763 |
|---|---|
| UOM | Pack of 10 |
| UNSPSC | 41104307 |
| Manufacturer Part Number | A139 |
| Product Dimensions | 8X8X8 Inches |
| Product Weight | 0.8 |
